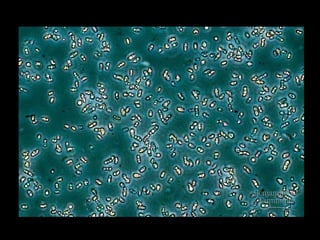

Embed presentation
Download to read offline








































Photosynthesis takes carbon dioxide and water and uses the energy from sunlight to produce oxygen and glucose through a complex process. Daniel Nocera, a chemist at MIT, has created catalysts that can mimic photosynthesis by using sunlight, water, and catalysts to produce hydrogen fuel. If Nocera's process of artificial photosynthesis can be scaled up efficiently, it could allow solar power to become a major global energy source by using sunlight and water to produce a storable fuel like hydrogen.